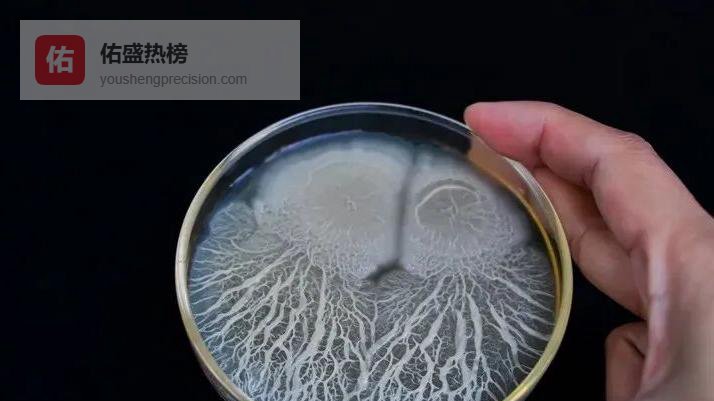

酵母:重塑水产饲料的核心力量
01从酿酒车间到养殖池塘——酵母的跨界革命
曾经,酵母只是啤酒和面包的“配角”;如今,它摇身一变,成为水产饲料中最具潜力的蛋白质来源。凭借免疫刺激与营养增益的双重光环,酵母正悄悄改写水产养殖的配方逻辑。

02营养底牌:单细胞里的“全价餐”
酵母虽小,却集齐了一切真核生物的“豪华配置”——线粒体、细胞核、内膜系统,全部完整封存。不同菌株(酿酒酵母、乳酸克鲁维酵母、孢圆酵母等)可按需提供32%–62%的粗蛋白,并附带赖氨酸、含硫氨基酸等限养氨基酸,以及B族维生素、叶酸等“隐形营养”。一句话:把“单细胞工厂”直接撒进水里,就能同步补给能量、蛋白与微量营养。

03实战效果:罗非鱼池塘里的“鱼粉替代实验”
1980年代起,科研团队就把酵母扔进罗非鱼饲料,观察生长、抗病与水质变化。结果令人惊喜:当鱼粉被部分或全部替换为酿酒酵母,罗非鱼的生长效率、抗病力与肠道菌群多样性同步提升。更关键的是,酵母降低了对鱼粉的依赖,为可持续饲料提供了“减碳”路径。
04免疫加持:酵母如何成为“隐形疫苗”
酵母细胞壁里的β-葡聚糖、甘露寡糖等成分,被证实能激活鱼类头肾白细胞、增强溶菌酶活性。以海鲷(Sparus aurata)为例,日粮中添加酵母后,病原挑战下的存活率提高近30%。换句话说,酵母把“营养”与“免疫”装进同一颗细胞,降低了额外投喂抗生素的成本。
05益生菌联盟:酵母+芽孢杆菌的“双骄”模式
水产养殖最头疼的莫过于“弧菌爆发”。把酵母与芽孢杆菌属菌株复配,真菌多糖与细菌孢子协同作用,可在池塘底部形成“生物屏障”,抑制有害菌繁殖。印度明对虾(Fenneropenaeus indicus)的试验显示,投喂海洋酵母β-葡聚糖后,免疫因子TNF-α水平提升近两倍,生长速率同步加快。

06活体饲料的新燃料:卤虫、轮虫也“吃”酵母
酵母还是活体饲料培养的“能量包”。当啤酒酵母作为卤虫主粮时,幼虫的孵化率与存活率分别提高15%与8%;轮虫的最佳摄食率被锁定在“0.3 g面包酵母/10⁶只轮虫”;桡足类密度更因酵母而翻倍。一条看似简单的酵母,直接打通了“饲料—活饵—幼体”的全链路。
07理性声音:完全替代为何仍需谨慎?
再优秀的替代品也有边界。虹鳟鱼实验发现,100%酵母蛋白导致尿酸堆积与轻微贫血;念珠菌属虽可替代40%鱼粉而不影响产量,却仍需更多数据验证长期肾功能。因此,“部分替代+精准配方”被视为当前最稳妥的策略:让酵母做“增量”,而非“全部”。
08未来展望:从实验室到每一个饲料袋
随着微生物组学、后基因组学工具的成熟,定制化酵母菌株正批量涌现——更高蛋白、更低尿酸、更强免疫刺激。可以预见,未来饲料袋上或许会出现“酵母含量”一栏,像如今标注蛋白含量一样清晰。届时,水产养殖将不再只是“喂鱼”,而是“喂活细胞”——而这颗细胞,正是酵母。




